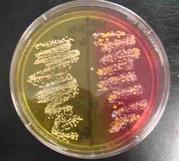

| ||||
Microbial Growth & Metabolism
Main Page
Virtual Microbiology Classroom of Science Prof Online
Microbial Metabolism & Growth Lecture Materials
These
are the Microbial Metabolism & Growth Lecture materials of the Virtual Microbiology Classroom (8-week &
16 week). The resources below are used to supplement an actual
college microbiology course.
These multiple choice and true/false questions are designed to help students practice and test their understanding of a variety of Microbiology subtopics.
SCIENCE PHOTOS
SPO VIRTUAL CLASSROOMS
 | ||||||
LEARNING OBJECTIVES
These lecture learning objectives are a study guide based on the VMC Microbial Metabolism & Growth Lecture PowerPoint Show:
- Understand difference between catabolism / anabolism and what these reactions have to do with metabolism.
- Understand the steps of aerobic cellular respiration to the detail that we discussed in class (starting molecule, end product molecule, what is produced in each pathway or subpathway. You do not need to know the name of every molecule at every substage of these processes).
- Understand how aerobic respiration, anaerobic respiration and fermentation differ.
- Understand how metabolism relates to the differential aspect of MacConkey's and Mannitol Salt specialized media.
- Explain what “microbial growth” means.
- Know the 4 phases of the microbial growth curve.
- Understand how microorganisms are grouped based on their relationship with oxygen, temperature, pH & osmotic pressure.
- How does bacterial generation time relate to characteristics of disease? (Another “think” question.)
- Understand what it means for binary fission to result in exponential growth.
- Understand the different factors that affect bacterial growth and how they influence the speed of population growth. Know any terminology associated with these factors.
- Know the microbes that we met in this lecture and their relevance to the topics discussed.
- Mycobacterium leprae and Generation time
- Listeria monocytogenes and Temperature
- Helicobacter pylori: pH & Oxygen
- Campylobacter jejuni and Oxygen
- Staphylococcus epidermidis & Osmostic Pressure
LECTURE POWERPOINT
Versions of Microbial Metabolism & Growth PPT:
- Student's Microbial Metabolism & Growth PPT Show
Printing: The best way for students to print out the PowerPoint Show is to download the PDF version. Select Print, and, when the Print screen comes up, go to the Print Handling options. Under Page Scaling, select "Multiple pages per sheet", under Pages Per Sheet, select "2". That uses up less paper, placing two slides on each page.
The Microbial Metabolism & Growth Lecture materials include:
- list of learning objectives
- PowerPoint lecture
- homework assignment
- practice test & review questions
- relevant microbiology photos
The differential aspect of
is based on microbial metabolism. MacConkey's Agar Gram-negative bacteria that can ferment the sugar lactose grow in pink colonies.
Virtual Microbiology Classroom provides a wide range of free educational resources including PowerPoint Lectures, Study Guides, Review Questions and Practice Test Questions.
Page last updated: 2/2016
How to Interpret MacConkey's Agar (MAC) Specialized
Bacterial Growth Medium
DIFFERENTIAL MEDIA & MICROBIAL METABOLISM HOMEWORK ASSIGNMENTS
These assignments will help reinforce your understanding of the relationship between differential media and microbial metabolism.
REQUIRED READINGS
Here is what you need to read, in addition to the PowerPoint, to master this topic. Check Moodle & your textbook for additional readings.
- Why Do We Breathe? Aerobic Cellular Respiration
- Cellular Metabolism: What Is Fermentation?
- What Is the pH Scale? Measurement of Acidity & Alkalinity
- Binary Fission: Cell Division & Reproduction of Prokaryotes
- Listeriosis: Listeria monocytogenes Psychrophilic Bacteria & Food Poisoning
PRACTICE TEST & REVIEW QUESTIONS
These multiple-choice / matching practice test questions and essay review questions are designed to help you better understand the material from this lecture.
- Microbial Metabolism [Practice Test Questions & Review Qus]
- Microbial Growth [Practice Test Qus Part I, Part II & Review Qus]
MICROBIAL METABOLISM & GROWTH IMAGES
The photographs linked here directly relate to this lecture material and are designed to help you review and study while outside of the laboratory.
MORE MICROBIAL METABOLISM & GROWTH LINKS
- Cellular Respiration animation by Jay Phelan, “What is Life? A Guide to Biology”
- How NAD+ Works animation and quiz from McGraw-Hill.
- Glycolysis animation and quiz from McGraw-Hill.
- Krebs Cycle Animation & Quiz 1 from McGraw-Hill.
- Krebs Cycle Animation & Quiz 2 from McGraw-Hill.
- Electron Transport Chain animation from Molecular & Cellular Biology Learning Center.
- Electron Transport Chain click through animation by Graham Kent Bio231 Cell Bio.
- Anaerobic Respiration Page by Timothy Paustain, University of Wisconsin, Madison.
- E. coli population growth time lapse video.
- Bacterial growth video and narration, YouTube, Dizzo95.
- Osmosis Demonstration with raw egg by THSharpe.
Time lapse video of
E. coli bacteria growing, viewed through microscope.